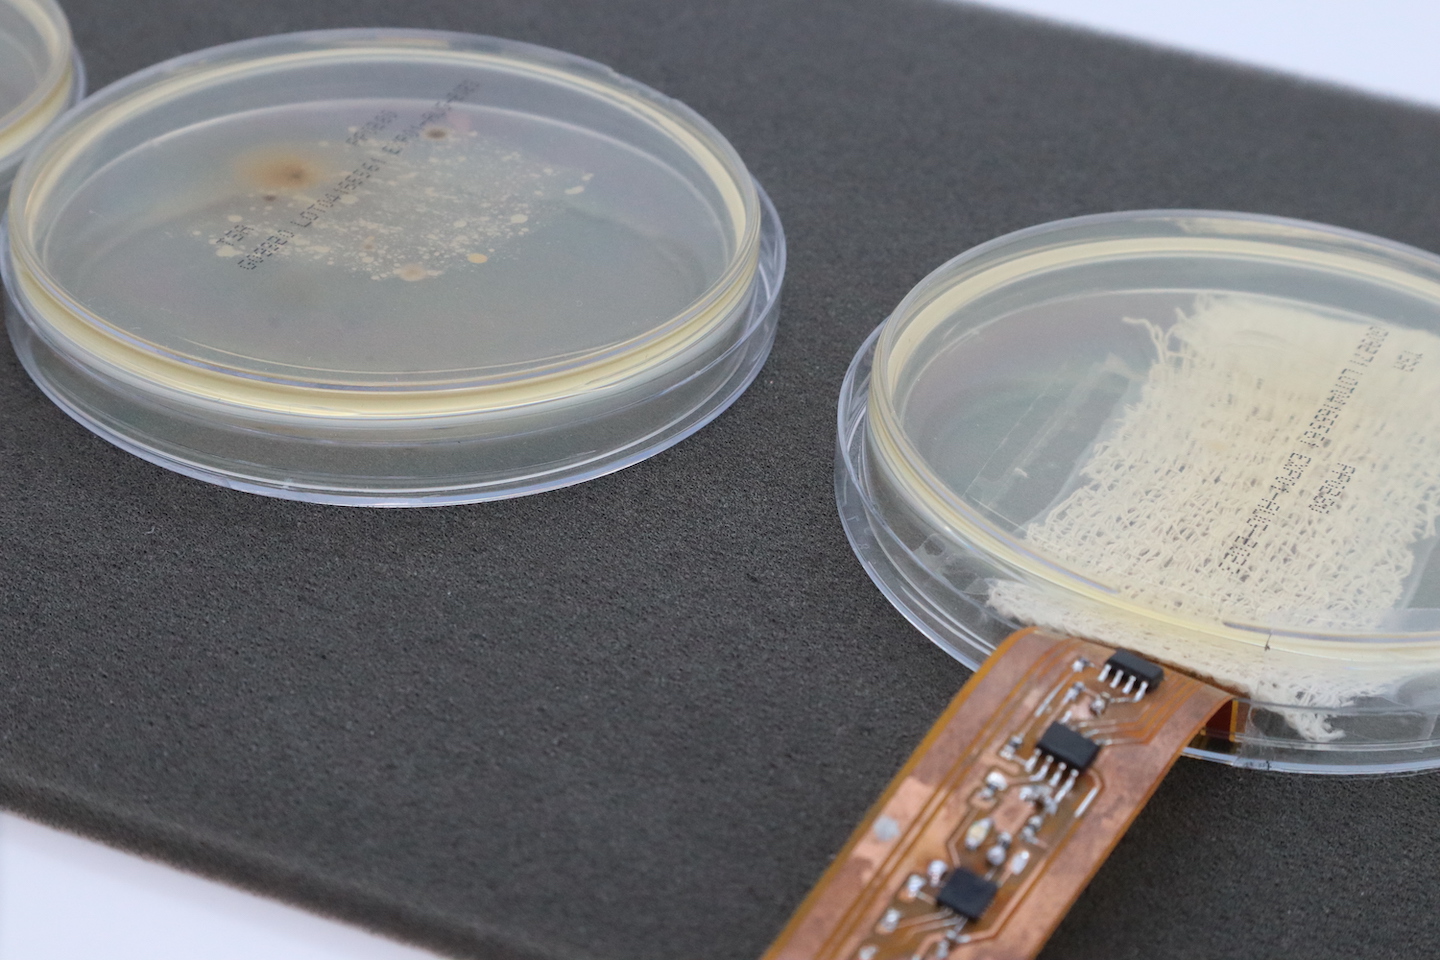
two petrie dishes sit side by side; one has a strip of metal embedded with electronics poking out of it like a tongue

This electronic bandage sterilizes wounds with flashes of light
Since it runs on wireless power, it needs no bulky batteries
A doctor bandages the head of a little boy at a hospital. New electronic bandages could soon provide antibiotic-free options to keep wounds germ-free as they heal.
ER Productions Ltd./DigitalVision/Getty Images Plus
A new electronic bandage kills germs with flashes of light. And good new: No antibiotics needed.
Embedded with tiny LED bulbs, the bandage emits light at ultraviolet-C, or UVC, wavelengths. Doctors and dentists often use this high-energy light to clean medical equipment. But sterilizing wounds with UVC hasn’t been so easy. The big hurdle: energy. A light-flashing bandage needs power. So typically, those bandages have needed a battery. (Otherwise, they would have to be plugged in.)
But powered by wireless technology, the new bandage needs no bulky batteries. That allows the device to fit comfortably and flexibly. It also means fewer used batteries end up in the trash, where they can leach chemicals that hurt the environment.
Educators and Parents, Sign Up for The Cheat Sheet
Weekly updates to help you use Science News Explores in the learning environment
Thank you for signing up!
There was a problem signing you up.
Electricity travels to the new bandage from a “powering coil” — a piece of fabric threaded with copper wires. Electric toothbrushes receive energy in a similar way when they sit in their charging cradles. “It’s the same principle,” says Stephen Beeby. He studies materials science at the University of Southampton in England. His group created the new bandage.
This team didn’t invent wireless power or light-emitting bandages. But it is the first time they’ve been used together, notes his co-worker Mahmoud Wagih. He studies sustainable electronics at the University of Glasgow in Scotland. This is “the first time someone has developed [a] UV antibacterial system that is entirely wireless,” he says.
Their team described its work in the May issue of IEEE Transactions on Biomedical Circuits and Systems.
An alternative to antibiotics
Wireless power makes the UV-based bandages more practical. Their light replaces the antibiotics typically used to kill germs. And having antibiotic-free options for wound care is a big deal.
Antibiotics save lives. But their long-term use brings problems. Many bacteria have adapted to survive in the presence of antibiotics. In the United States alone, more than 2.8 million people develop infections resistant to antibiotics each year. (More than 35,000 of them die.) The so-called “superbugs” behind these infections can lead to non-healing wounds. People with certain diseases — such as diabetes or cancer — face the greatest risk of such long-lasting wounds.
Tech advances, such as this new bandage, might help limit this issue.
From the outside, the new bandage doesn’t look all that novel, Beeby admits. But tucked inside is a coil — a flexible strip of LED-studded electronics. This coil is what emits the light.

When it’s time to apply a clean dressing to a wound, just take out the electronic coil and slip it inside a new fabric bandage, Beeby says. You throw away the old bandage, but not the electronics. Think of that fabric dressing as a “kind of vehicle for the electronics,” he explains.
Once applied, the bandage periodically flashes the surface of the wound with UV light. Those high-energy rays zap any lurking germs.
The team tested the ability of their device to kill microbes in a petri dish for more than six hours. They exposed bacteria to different levels of UVC from the bandage. Lower-intensity light stopped the bacteria from reproducing. Higher intensity levels killed the microbes.
A doctor might even customize the bandage to the wound, says Beeby. A deep wound, for example, might need higher-intensity flashes than a shallow infection.
Limited range at this time
Amirhossein Hajiaghajani studies wireless power at the University of California, Irvine. He sees potential in this new bandage — but also some hurdles to its widespread use. Chief among those hurdles: the device’s relatively short range.
To work, the bandage must be within range of its wireless energy source, that powering coil. “That’s important,” says Wagih, because while the bandage may not have a battery, that powering coil does.
Right now, the bandage must be within about 20 to 30 centimeters (8 to 12 inches) of the coil, says Wagih.
To Hajiaghajai, who is not involved in the project, “that range is very limited.”
Beeby and Wagih do agree. An important next step will be extending the range of that wireless power. But Beeby already sees a place where the device could find use. Imagine a patient in bed, Beeby says. “The coil could be embedded [in] the sheet.”
To the farm, and beyond
Extending the bandage’s range will improve the device. But even now, it offers some advantages over traditional bandages.
For instance: The team developed this bandage for people. But imagine using it for animals, says Wagih. A bandage for pets, perhaps? Or even farm animals, he suggests. Already farm use of antibiotics is a major contributor to antibiotic resistance worldwide. Farms are “really an environment where you do not want to be using antibiotics,” Wagih says.
This is one in a series presenting news on technology and innovation, made possible with generous support from the Lemelson Foundation.